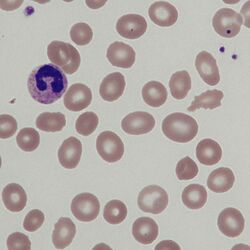

Elliptocytes
From haematologyetc.co.uk
Derivation: a flattened circle; in morphological usage the word tends to be applied to cells that are significantly elongated (length>twice the diameter)
Appearance
Elliptocytes have an elliptical or “cigar-shaped” form – the key is that the cell is rounded and not curved (in contrast to the sharp-ended and curved sickle cell.
Images: The appearance is a “flattened circle” – this means that the overall rounded shape should be retained (unlike the sharp-ended sickle cell) and the outline should be regular unless affected by additional damage. Generally, the term elliptocyte should be used only for cells where length is greater than twice width, but often these cells will be part of a spectrum with some more oval forms. In cases that are not hereditary it is important also to look for indications of the underlying pathology (e.g. haematinic deficiency).
Significance
Elliptocytes commonly form part of the spectrum of abnormal cells when haematopoiesis is disordered (e.g. iron deficiency or chronic disease), but in such cases are rarely the most predominant cell form. In inherited elliptocytosis these cells are the sole or predominant feature, although numbers can vary from relatively few affected cells to involve almost all cells. In cases where multiple membrane defects co-exist very severe morphological abnormality can arise (hereditary pyropoikilocytosis).
Pitfalls
Typical elliptocytes form part of a spectrum of elongated forms, that may variously be described as oval or cigar-shaped. The distinction between these forms is often subjective, but as a rule of thumb, a cell can be considered to be an elliptocyte if its long-axis is twice the length of its short-axis. Other forms of elongated cell have specific names (see ovalocytes and pencil cells). Note also the blunt rounded end that distinguishes these cells from the curved and sharpened Sickle cells.
Causes
| Inherited defects |
|---|
| Hereditary elliptocytosis Elliptocytes are the major or predominant feature on the blood film: Generally defective association of spectrin into tetramers or impaired anchorage of spectrin to other proteins of the erythrocyte membrane. Most commonly caused by mutations affecting the beta subunit of spectrin. |
| Hereditary pyropoikilocytosis: Severe membrane instability produces both elliptocytes and greatly distorted or fragmented cells. These conditions often involve homozygosity for spectrin defects or the combination of spectrin defects and a separate inherited abnormality of membrane proteins. |
| Other causes |
| Elliptocytes present together with a range of other cell types: A smaller number of elliptocytes occur when red cells are damaged in other conditions including thalassaemia, myelofibrosis and haematinic deficiency (megaloblastic anaemia or iron deficiency). |
Clinical Examples
Clinical Image 1: Almost all cells are elongated with a rounded shape and retained central pallor. There are also mant partial elliptocyes (ovalocytes) - this spectrum of shape typical of inherited elliptocytosis. In less severe cases there may be fewer cells affected. Clinical condition: hereditary elliptocytosis.
Clinical Image 2: Elliptical cells present in a patient with severe chronic disease (lung cancer). Note the marked variability of cell form with many cells being oval and relatively few definite elliptocytes. Note also the presence of smaller dense cells and one tear-drop shaped crenated cell. Clinical condition: anaemia of chronic disease
Clinical Image 3: Several elliptical cells are present on this film including one very long “pencil cell”. In this case elliptocytes are clearly present, but the most prominent feature is the marked hypochromia and the pencil cell is part of this process reflecting severe iron deficiency. Clinical condition: iron deficiency
Clinical Image 4: This film has elliptical cells present, but in the context of marked variability of cell shape including a nucleated erythrocyte and many small or damaged cells. This is hereditary pyropoikilocytosis (usually caused by two inherited abnormalities of membrane or by homozygous spectrin abnormailites (see causes). Clinical condition: hereditary pyropoikilocytosis
Pathobiology
Inherited elliptocytosis derives from defects of the cytoskeleton that most frequently involve defective association between spectrin fibrils (these link the structures on the inside of the membrane reinforcing cell structure). This makes the cytoskeleton less resistant to shear stress, and subject to permanent deformation as cells age. However, occasional elliptocytes may also arise in response to other forms of red cell damage, and are seen as part of the spectrum of changes in a range of conditions.